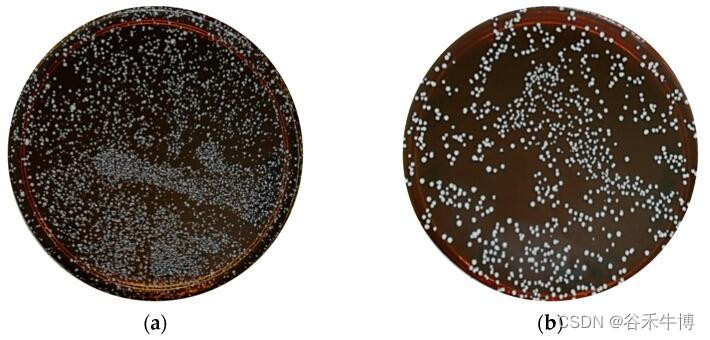

谷禾健康

乳杆菌属(Lactobacillus)是厚壁菌门乳杆菌科下的一类革兰氏阳性菌,最早于19世纪在酸奶中发现。
乳杆菌在自然界中分布很广,在植物体表、乳制品、肉制品、葡萄酒、发酵面团、污水以及人畜粪便中,均可分离到。在人类中,乳杆菌属成员定植于胃肠道、口腔和女性泌尿生殖道。
★ 乳杆菌的特性
• 消化和代谢蛋白质和碳水化合物
• 合成B族维生素和维生素K
• 分解代谢胆汁盐
• 增强先天性和获得性免疫力
• 抑制促炎介质
• 对一系列病原体具有抗菌活性
✦乳杆菌的应用
乳杆菌被广泛应用于各种领域中:
•食品工业
乳杆菌被广泛应用于食品工业中,如酸奶、奶酪的制作中。乳杆菌能够发酵乳糖产生乳酸,使得食品呈现出酸味和口感。
•医药领域
乳杆菌被用于制作口服制剂、肠内营养制剂、抗生素辅助治疗等药物。能够调节肠道微生物群落的平衡,促进食物消化和营养吸收,缓解肠道炎症和感染。
•保健品领域
乳杆菌被应用于保健品领域,如乳酸菌饮料、乳酸菌片等。乳杆菌能够改善肠道菌群平衡,增强免疫力,促进身体健康。
•环境领域
乳杆菌被应用于环境领域,如土壤修复、废水处理等。乳杆菌能够分解有机物质,促进土壤肥力和水质净化。
★ 乳杆菌对人体健康非常重要
随着对微生物群落的研究逐渐深入,乳杆菌的作用也逐渐被人们所认识。
乳杆菌对人体有着重要的作用,在肠道健康及女性阴道健康中扮演不可或缺的角色。具有多种生理功能,能够维护菌群平衡、改善消化功能、提高免疫力,除此之外还会影响一些疾病的进展。
本文主要讨论和介绍乳杆菌的菌属特性,生态代谢特征,对人体肠道健康、阴道健康以及一些疾病的影响,在最后还介绍了一些补充乳杆菌的方法。
目录/contents
Part1:认识乳杆菌
Part2:乳杆菌与肠道健康
Part3:乳杆菌与阴道健康
Part4:乳杆菌与其他疾病
Part5:如何补充乳杆菌
Part6:结语
01
认识乳杆菌
▸ 乳杆菌、乳酸杆菌和乳酸菌
乳杆菌属(Lactobacillus),有时也会翻译成乳酸杆菌,是革兰氏阳性兼性厌氧或微需氧的棒状细菌,通常是乳酸菌的一种。
乳杆菌属包括多种菌种,如乳酸杆菌、嗜酸乳杆菌、肠道乳杆菌等。它们通常是革兰氏阳性、非芽孢杆菌,能够在无氧或微氧条件下进行发酵,产生乳酸等有益物质。
乳酸菌包括多种菌属,如乳杆菌属、双歧杆菌属、嗜酸乳球菌属等。它们能够在无氧或微氧条件下进行发酵,产生乳酸等有益物质。乳酸菌在人体内具有多种功能,如维护肠道菌群平衡、增强免疫力、促进营养物质吸收等。
因此,乳杆菌属(乳酸杆菌)是乳酸菌的一种,而乳酸菌则是一个更广泛的概念,包括多种菌属。
▸ 形态特征
乳杆菌属于革兰氏阳性菌,呈细长的杆状,但无分枝,无芽孢,一般大小约为0.5-1.5μm×2-10μm(某些大杆菌如保加利亚乳杆菌可能更大)。菌落呈圆形、白色(有时黄色)、半透明。
细胞壁:乳杆菌的细胞壁主要由肽聚糖和多糖组成,具有较强的抗菌作用。
运动性:乳杆菌通常是非运动性的,即不具有鞭毛或纤毛。菌毛首先在鼠李糖乳杆菌(Lactobacillus rhamnosus GG)中观察到,它从细菌细胞中突出,在粘附到上皮细胞中起主要作用。
乳杆菌菌落
Talib N,et al.Molecules.2019
注:a是在MRS培养基上从开菲尔样品中分离的乳酸杆菌菌落; b是在MRS培养基上从开菲尔样品中单筛选分离的乳酸杆菌
▸ 分类及主要种群
乳杆菌属是乳杆菌科中最大的一个属。该属的成员已经有超过200种。具体见附录一。
主要有德氏乳杆菌保加利亚亚种(保加利亚乳杆菌)、嗜酸乳杆菌、干酪乳杆菌、罗伊氏乳杆菌、惰性乳杆菌等。
此外卫生部公布可用于生产普通食品的乳杆菌还有卷曲乳杆菌、德氏乳杆菌乳亚种、发酵乳杆菌、格氏乳杆菌、瑞士乳杆菌、约氏乳杆菌、副干酪乳杆菌、植物乳杆菌、唾液乳杆菌等。
乳杆菌属中最具代表性的物种以其在食品发酵中的应用而闻名,并且特定菌株已被认为具有益生菌特性。乳酸杆菌的健康方面促使许多研究人员积极筛选这些细菌的许多潜在来源。因此,在过去 15 年中观察到新物种的爆炸式增长。
尽管许多早期描述的物种被转移到新创建的属(Atopobium、Carnobacterium、Eggerthia、 Weissella 、Fructobacillus等)该属在系统发育和表型标记方面仍然存在异质性。Pediococcus属、Paralactobacillus 属与Lactobacillus 混合在一起,表明对该属进行进一步的分类学细分很可能甚至是必要的。
▸ 生长环境和条件
乳杆菌广泛存在于自然界中,包括土壤、水体、植物、动物等环境中。乳杆菌作为一种常见的益生菌,也存在于人体的口腔、肠道、阴道等部位。
乳杆菌的生长环境主要包括以下几个方面:
pH值:乳杆菌适宜生长的pH范围一般在4.5-6.5之间(某些耐酸种群可能在3.8仍能生长),其中以5.5-6.0最为适宜。
温度:乳杆菌的生长温度一般在20-45℃之间,其中以30-40℃最为适宜。
氧气需求:乳杆菌是一种厌氧菌,不需要氧气就能生长。
营养物质:乳杆菌需要一定的营养物质才能生长,主要包括碳源、氮源、矿物质、维生素等。
注:不同种类的乳杆菌对营养物质的需求可能会有所不同
▸ 乳杆菌的代谢
乳杆菌是过氧化氢酶阴性革兰氏阳性微生物,主要产生乳酸作为碳水化合物发酵的主要代谢终产物。
参与的KEGG途径具体见附录二。
▸ 乳杆菌的作用
乳杆菌是一种益生菌,对人体健康有着重要的作用。以下是乳杆菌的主要作用:
维护肠道菌群平衡:乳杆菌能够抑制有害菌的生长,维护肠道菌群平衡,防止肠道感染和炎症。
改善消化功能:乳杆菌能够分解食物中的纤维素和其他难以消化的物质,促进食物消化和营养吸收。
提高免疫力:乳杆菌能够增强肠道黏膜屏障的功能,防止有害物质进入血液循环,提高免疫力。
缓解过敏反应:乳杆菌能够调节免疫系统的反应,减轻过敏反应的症状。
降低胆固醇:乳杆菌能够降低血液中的胆固醇水平,预防心血管疾病。
改善口腔健康:乳杆菌能够抑制口腔中有害菌的生长,预防龋齿和口臭。
总之,乳杆菌对人体健康有着多方面的益处,是一种非常重要的益生菌。
• 乳杆菌也有可能是机会性病原体
乳杆菌中主要的病原菌或致病菌包括:
- Lactobacillus fermentum
- Lactobacillus gasseri
- Lactobacillus hilgardii
- Lactobacillus iners
- Lactobacillus brevis
- Lactobacillus rhamnosus
- Lactobacillus crispatus
- Lactobacillus paracasei
- Lactobacillus fructivorans
它们也有可能是机会性病原体,可引起脓肿、菌血症、心内膜炎、肺部感染和新生儿脑膜炎等多种感染。
注:大多数由乳酸杆菌引起的疾病都发生在免疫功能低下的人或那些有糖尿病等易感病症的人身上。
乳杆菌在人体的位置及与人体的关系

Zafar H,et al.Genes (Basel).2020
▸ 乳杆菌的表面活性分子
乳杆菌的益生菌特性被认为是由乳杆菌表面活性分子 (SAM) 贡献的。据报道,支持益生菌作用的表面活性分子包括肽聚糖、细菌多糖和磷壁酸等。
乳杆菌细胞表面结构

Dempsey E,et al.Front Immunol.2022
通常,乳杆菌的细胞质膜被肽聚糖和其他生物聚合物包围,即磷壁酸、S层蛋白和多糖。
• 肽聚糖
肽聚糖(PG)是一种生物聚合物,包含由N-乙酰氨基葡萄糖(GlcNAc)和N-乙酰胞壁酸(MurNAc)侧链连接的聚糖链,形成革兰氏阳性菌(如乳杆菌和双歧杆菌)的细胞表面。
改善宿主先天免疫
乳杆菌肽聚糖在改善宿主先天免疫反应方面表现出出色的免疫调节活性。例如,干酪乳杆菌(L.casei)肽聚糖能够通过toll样受体2和核苷酸结合寡聚化结构域2(NOD2)诱导小鼠腹腔巨噬细胞产生白细胞介素12。
此外,植物乳杆菌(L. plantarum CAU1055)肽聚糖通过抑制一氧化氮合酶、环氧合酶-2(COX-2)和细胞因子(TNF-α和白细胞介素-6),显示出改善小鼠巨噬细胞中一氧化氮诱导的炎症的能力。
• 脂磷壁酸
乳杆菌肽聚糖通常用磷壁酸或脂磷壁酸修饰。脂磷壁酸由磷酸甘油的聚合产生,并与细胞质膜结合。
调节宿主的信号通路
脂磷壁酸与其他表面活性分子一起调节宿主模式识别受体和宿主的几种信号通路,这些信号通路是乳杆菌的益生菌和抗病原体作用的原因。
植物乳杆菌脂磷壁酸显著抑制粪便大肠杆菌生物膜的形成,并在人类牙本质切片上形成生物膜,这表明脂磷壁酸可以作为粪便大肠杆菌感染的预防和治疗措施。
• 细菌多糖
细菌在细胞表面形成紧密连接的聚合物,并将其作为胞外多糖(EPS)(松散未附着的黏液)释放到环境中。
细菌分泌的胞外多糖对于宿主-微生物相互作用过程中的粘附和细胞识别至关重要。乳杆菌的胞外多糖还能抑制蜡样芽孢杆菌(Bacillus cereus)产生的细菌毒素。
▸ 影响乳杆菌的因素
乳杆菌对人体健康有着重要的作用。然而乳杆菌的数量和种类受到多种因素的影响,包括以下几方面:
饮食因素:饮食中富含益生元的食物,如蔬菜、水果、全麦面包等,可以促进乳杆菌的生长。相反,高脂肪、高糖、高盐等不健康的饮食习惯会抑制乳杆菌的生长。
药物因素:长期使用抗生素、非甾体抗炎药等药物会破坏肠道菌群平衡,抑制乳杆菌的生长。
生活方式因素:缺乏运动、长期处于压力状态等生活方式因素也会影响肠道菌群的平衡,抑制乳杆菌的生长。
年龄因素:婴幼儿期肠道菌群构成不稳定,乳杆菌数量较少,随着年龄的增长,乳杆菌数量逐渐增加。
综上所述,保持健康的饮食习惯、合理使用药物、积极的生活方式等都有助于促进乳杆菌的生长。
02
乳杆菌与肠道健康
乳杆菌已被证明对改善胃肠道健康具有重要作用,本章节将具体展开讲述。
▼ 乳杆菌和肠道屏障完整性
胃肠道粘膜是机体最大也是最关键的屏障部位之一,外来抗原、微生物和潜在病原体都在这里与宿主的免疫系统密切接触。
它是一种半透性屏障,允许吸收营养和免疫感应,同时限制潜在有害抗原或微生物的流入。
胃肠道屏障由四个主要元素组成:共生微生物群、粘液层——含有分泌型免疫球蛋白A(sIgA)和抗微生物肽、肠上皮细胞单层和肠道相关淋巴组织(GALT)构成胃肠道隔室中的各种免疫细胞群。
肠道屏障破坏与多种疾病相关
肠道屏障功能的丧失被认为是各种胃肠道疾病发病机制的早期事件,例如乳糜泻和炎症性肠病,以及包括I型糖尿病、肥胖症和多发性硬化症在内的全身性疾病。所以肠道屏障的完整性对于健康至关重要。
★ 乳杆菌可以增强肠道屏障
肠道屏障功能可以通过摄入非致病微生物来增强,这些微生物可以增强粘液层的物理屏障,增强对病原体的先天防御并降低肠上皮细胞的细胞旁通透性。
作为益生菌食用的乳杆菌被认为可以通过多种作用机制调节天然肠道微生物群并改善健康。如图所,益生菌通过增加粘液的产生、刺激抗微生物肽的释放和分泌性免疫球蛋白A的产生来增强肠道屏障功能,增加肠上皮细胞的紧密连接完整性并提供对病原体的抵抗力。
乳杆菌增强肠道屏障的机制

Dempsey E,et al.Front Immunol.2022
1 粘液分泌
胃肠道的杯状细胞表达杆状粘蛋白,这些粘蛋白要么粘附在上皮细胞上,要么释放到胃肠道腔中。这些粘蛋白高度糖基化并通过二硫键连接在一起形成糖蛋白基质,保护肠上皮免受肠腔内容物(含有消化酶)的影响,防止致病抗原/细菌与上皮单层之间的相互作用,并有助于胃肠道运动。
粘液层的厚度通常在50-800µm之间,在健康个体中,最靠近上皮表面的前30µm应该没有微生物。
乳杆菌通过促进粘液分泌增强胃肠道屏障
乳酸菌种被认为通过促进粘液分泌来增强肠道屏障防御。体外研究表明,来自干酪乳杆菌(L.casei T21)的条件培养基可以上调受到艰难梭菌攻击的结肠上皮细胞中的粘膜保护性基因。
在体内研究方面, L. rhamnosus CNCM I-3690 最近被证明可以保护或恢复杯状细胞种群并保护小鼠在低度结肠炎症后的粘液层厚度。
类似地,施用两种罗伊氏乳杆菌(L. reuteri R2LC 或4659)菌株之一并暴露于结肠炎的小鼠表现出降低的结肠炎严重程度,归因于给予益生菌的小鼠粘液厚度增加。
2 抗菌肽、抗菌因子
宿主产生的胃肠道抗菌肽通常分为导管素和防御素。抗菌肽可以被丁酸盐激活。
丁酸盐由肠道微生物群产生,但很少有研究检查益生菌对导管素表达的影响。
防御素进一步分为β-防御素,由整个肠道的上皮细胞产生,以及α-防御素,在小肠中表达。防御素在胃肠道中组成型表达,对许多细菌、真菌和一些病毒显示出抗微生物活性。
乳杆菌诱导抗菌肽表达
嗜酸乳杆菌(L. acidophilus PZ1138)和发酵乳杆菌(L. fermentum PZ1162)显示可通过促炎机制在细胞中诱导人β-防御素-2基因的表达。除了上调促炎介质外,给肉鸡施用罗伊氏乳杆菌(L.reuteri)还与盲肠和回肠中的抗菌肽调节相关。
除了宿主衍生的抗菌肽刺激外,共生细菌还产生抗菌因子以帮助宿主屏障防御。这些因素包括短链脂肪酸、过氧化氢和细菌素。
短链脂肪酸刺激紧密连接的形成
乳杆菌产生包括乙酸盐、丙酸盐和丁酸盐在内的短链脂肪酸,这些短链脂肪酸已被证明在体外通过抑制NLRP3炎症小体和自噬来增加跨上皮电阻并刺激肠上皮细胞中紧密连接的形成。
细菌素抑制或杀死其他细菌
细菌素是由多种细菌产生的核糖体合成的热稳定肽,其功能是抑制或杀死其他细菌的生长。
革兰氏阳性菌产生的细菌素通常通过破坏膜功能发挥其抗生素作用,通常针对其他革兰氏阳性菌,但一些革兰氏阴性菌也可能易感。
植物乳杆菌产生多种细菌素,这些细菌素对食源性病原体(如李斯特菌)和食品腐败菌具有抗微生物活性,可用于食品生产以减少化学防腐剂的使用。
3 免疫球蛋白A
免疫球蛋白A的产生是胃肠道在非炎症模式下产生免疫保护的重要方式。IgA二聚体(由位于淋巴结或固有层的肠道B细胞分泌)与上皮细胞基底外侧表面的受体相互作用,转移到上皮细胞表面并作为分泌型免疫球蛋白A(sIgA)释放。
分泌型免疫球蛋白A(sIgA)是一种非常重要的抗体分子,在人体抵抗疾病的第一道防线起决定性作用。
sIgA主要通过结合饮食抗原和粘液中的潜在病原体并下调共生细菌上促炎细菌表位的表达来促进肠道中合适的共生细菌群落的维持。
此外,sIgA通过阻断参与上皮粘附的微生物成分增强肠道屏障,促进上皮内防御病原体和微生物产物。
乳杆菌可以增加小肠中slgA水平
已知包括副干酪乳杆菌(L.paracasei MCC1849)、加氏乳杆菌(L.gasseri SBT2055)和植物乳杆菌在内的各种乳杆菌菌株可增加小肠中的sIgA水平。
在一项针对12至24个月大儿童的临床试验中,补充植物乳杆菌增加了sIgA粪便滴度,并且观察到这与TGF-β1/TNF-α比率之间存在显著正相关。
4 上皮细胞屏障
如前所述,肠上皮细胞形成单层细胞,充当肠腔外部环境和宿主免疫系统之间的物理屏障。该屏障的完整性由紧密连接确保,紧密连接是将细胞紧密结合在一起的多蛋白复合物以及粘附连接、间隙连接和桥粒。
紧密连接位于上皮细胞的顶端侧。它们由跨膜蛋白组成,这些蛋白在细胞外与邻近细胞中紧密连接的类似蛋白质相互作用,在细胞内通过封闭小带蛋白和丝状肌动蛋白与细胞自身的细胞骨架相互作用。
病原菌感染会破坏紧密紧密连接蛋白
在慢性炎症性疾病中观察到紧密连接完整性的丧失,在肠道病原体如艰难梭菌、大肠杆菌、鼠伤寒沙门氏菌、霍乱弧菌等的感染中观察到破坏紧密连接蛋白以突破胃肠道屏障的机制。
乳杆菌增强紧密连接蛋白和闭合蛋白表达
已证明鼠李糖乳杆菌上调Caco-2细胞中的紧密连接蛋白1(ZO-1)的表达。这种益生菌菌株可提高ZO-1的表达水平并增强闭合蛋白(claudin-1)的分布,作为对抗肠出血性大肠杆菌感染的保护机制。
使用各种植物乳杆菌菌株(L. plantarum WCSF1、L. plantarum CGMCC 1258和L. plantarum MB 452)也观察到紧密连接蛋白和闭合蛋白的表达增加。
乳杆菌增强肠上皮屏障保护作用

Hou Q,et al.Cell Death Differ.2018
增加E-钙粘蛋白表达,稳定粘附连接
乳杆菌还可以通过增加E-钙粘蛋白的表达,以及通过增强β-连环蛋白的磷酸化来加强E-钙粘蛋白/β-连环蛋白复合物(将粘附连接到细胞骨架)来稳定粘附连接。
钙黏蛋白E——又名上皮细胞钙粘素和CD324,是一种钙依赖性的细胞粘附分子。
在小肠屏障功能的临床研究中,活检样本表明植物乳杆菌(L. plantarum strain TIFN101)和较小程度上L. plantarum WCFS1和CIP104448调节紧密连接和粘附连接蛋白基因表达的增加。
5 竞争结合位点抵抗病原体
乳杆菌还通过竞争肠上皮细胞、粘液层中的糖蛋白或细胞外基质的纤溶酶原上的结合位点来帮助肠道屏障抵抗入侵病原体。
为了促进与宿主细胞的相互作用,乳杆菌属物种在其外表面展示各种不同的成分。这些可能包括细胞壁蛋白、S层蛋白、菌毛蛋白和月光蛋白。
这些表面蛋白促进乳杆菌与宿主的粘附,例如在几种乳杆菌菌株中发现的LPXTG蛋白是与肽聚糖层共价结合的细胞表面蛋白,可以结合粘液和上皮细胞。
通过阻断病原体与位点结合显示抗病毒活性
嗜酸乳杆菌(L. acidophilus ATCC)的S层蛋白通过阻断病原体与C型凝集素受体(DC-SIGN)的粘附而显示出抗病毒活性
C型凝集素受体(DC-SIGN)是一种强烈促进病毒感染的附着因子
▼ 乳杆菌和胃肠道感染
如前文所述,乳杆菌通过促进粘液产生和屏障相关蛋白,分泌抗微生物物质(如短链脂肪酸、细菌素)抑制病原体的生长或杀死病原体,来保护肠道屏障免受感染,并通过调节宿主对病原体的免疫反应,防止病原体粘附和竞争结合位点。
★ 乳杆菌可以抑制病原菌感染
因此,乳杆菌能够预防某些细菌感染引起的肠道损伤。乳杆菌已被证明可以抑制病原菌感染的发展,例如艰难梭菌和产气荚膜梭菌、空肠弯曲杆菌、肠炎沙门氏菌、大肠杆菌、金黄色葡萄球菌和耶尔森氏菌等。
由感染引起的两种主要胃肠道疾病,幽门螺杆菌感染和抗生素相关性腹泻,已被证明可以极大地受益于乳杆菌,概述如下。
幽门螺杆菌感染与乳杆菌
幽门螺杆菌感染是世界上最常见的细菌感染之一,全球一半以上的人口受到感染。幽门螺杆菌感染胃的上皮细胞内壁,导致消化性溃疡病、慢性胃炎和胃癌等疾病。
许多感染者没有症状,20%的感染患者会出现胃炎症状、胃或十二指肠溃疡或非霍奇金胃淋巴瘤。
目前推荐的幽门螺杆菌感染治疗方法包括多种抗生素药物和质子泵抑制剂,但随着幽门螺杆菌抗生素耐药性的上升,这种治疗的有效性正在下降。
在各种随机对照试验中,添加乳杆菌(分别为干酪乳杆菌DN-114 001和干酪乳杆菌Shirota)和嗜酸乳杆菌后生元已被证明可以提高该疗法的疗效。
√使幽门螺杆菌活力丧失
来源于干酪乳杆菌(Lactobacillus caseistrain Shirota)的无细胞废培养上清液在体外表现出对幽门螺杆菌的杀菌活性。约氏乳杆菌(L. johnsonii NCC533)和嗜酸乳杆菌均导致幽门螺杆菌活力丧失。
此外,来自这三种乳杆菌菌株的培养物上清液导致幽门螺杆菌的形态改变为U形或球形体,这是细菌的休眠形式,而球形体定植和诱导炎症的能力较低。
已知约氏乳杆菌NCC 533和干酪乳杆菌Shirota也能产生对幽门螺杆菌有活性的细菌素。
√影响幽门螺杆菌运动
幽门螺杆菌是一种螺旋形细菌,具有多个鞭毛,使其能够在胃粘液层中游动并与上皮细胞相互作用,这是在胃中定植所需的能力。
干酪乳杆菌已被证明会导致幽门螺杆菌失去鞭毛运动,这是由于其转化为没有鞭毛的休眠形式,以及通过分泌抑制游泳能力的小型抗微生物化合物。
类似地,约氏乳杆菌(L. johnsonii NCC533)也分泌抑制幽门螺杆菌游泳能力的化合物。
√阻止幽门螺杆菌粘附
为了在胃的低pH中生存,幽门螺杆菌将脲酶表达为一种表面蛋白,以中和周围的酸性环境。嗜酸乳杆菌和约氏乳杆菌的培养物上清液已被证明可降低幽门螺杆菌的脲酶活性。
就粘附性而言,嗜酸乳杆菌阻止了幽门螺杆菌粘附到人HT-29细胞上,导致粘附细胞死亡,并降低了导致其裂解的剩余粘附细胞的脲酶活性。
HT-29细胞——人结直肠腺癌细胞
抗生素相关性腹泻与乳杆菌
抗生素相关性腹泻 (AAD) 是由抗生素破坏肠道正常微生物群引起的,其症状从轻度腹泻到更严重的疾病,如伪膜性结肠炎 (PMC) 。
抗生素相关性腹泻发生在5-30%接受抗生素治疗的患者中,无论是在抗生素治疗期间还是在治疗停止后长达2个月内。
与抗生素相关性腹泻相关的主要病原体之一是艰难梭菌,它导致10-30%的轻症病例和90-100%的重症病例。
注:尽管产气荚膜梭菌、金黄色葡萄球菌和催产克雷伯氏菌等其他微生物与这种疾病有关,但它们并不常见。
√乳杆菌治疗是预防抗生素相关性腹泻的有效措施
虽然在这种情况下益生菌的作用机制尚不清楚,但它们的功效似乎是维持肠道菌群、战胜病原菌、保护肠道屏障功能和潜在的免疫调节。用包括鼠李糖乳杆菌和格氏乳杆菌(L. gasseri)在内的几种乳杆菌菌株治疗已被证明是治疗抗生素相关性腹泻的有效预防措施。
一项分析总结了51项随机对照试验,发现鼠李糖乳杆菌比其他益生菌更有效,但干酪乳杆菌对艰难梭菌感染最有效。另一项研究显示了类似的结果,得出结论认为安全地给予鼠李糖乳杆菌以预防抗生素相关性腹泻并另外控制急性胃肠炎的症状。
▼ 乳杆菌与肠道炎症
前文中有提到乳杆菌在宿主的胃肠道中发挥免疫作用,可增强肠道屏障并保护免受潜在病原体的侵害。
✦乳杆菌的免疫调节作用
乳杆菌的免疫调节作用是通过释放细胞因子实现的,包括白介素、肿瘤坏死因子、干扰素、转化生长因子和来自免疫细胞的趋化因子。
炎症过程取决于促炎细胞因子与抗炎细胞因子,益生菌可以通过这种方式以免疫调节或免疫刺激的方式发挥作用。
降低炎症反应
免疫调节益生菌可降低炎症反应,保护宿主免受自身免疫性疾病、炎症性肠病和过敏的侵害,其特点是产生白细胞介素-10和调节性T细胞。
白细胞介素-10是由单核细胞、T细胞、B细胞、巨噬细胞、NK细胞产生的抗炎细胞因子,可抑制促炎细胞因子、趋化因子和趋化因子受体,从而防止肠道炎症。
免疫刺激性益生菌通过产生白细胞介素-12来激活NK细胞和发育Th1细胞,保护宿主免受感染和癌症发展,并通过平衡Th1和Th2的产生来保护宿主免受过敏。
越来越多的证据表明,乳杆菌有可能预防或治疗某些炎症性疾病:
下调白细胞介素12的产生
L.casei Shirota、L.johnsonii JCM 2012 和L.plantarum ATCC 14917的肽聚糖已被证明可通过Toll样受体2下调白细胞介素-12的产生。
增强了免疫反应
来自鼠李糖乳杆菌(L.rhamnosus CRL1505)的肽聚糖在小鼠鼻腔给药时表现出先天性和适应性免疫反应的增强,改善了Th2型免疫反应。
引发抗炎反应
植物乳杆菌的脂磷壁酸已被显示通过抑制 白细胞介素-8在人和猪肠上皮细胞中引发抗炎反应。
鼠李糖乳杆菌的菌毛的敲除突变体表明,这些菌毛不仅对粘附至关重要,而且具有免疫调节作用。
在小鼠中,源自德氏乳杆菌保加利亚亚种发酵酸奶的胞外多糖具有免疫刺激作用,激活自然杀伤细胞并诱导脾脏产生γ干扰素。
✦乳杆菌代谢物的免疫调剂作用
短链脂肪酸的抗炎作用
一些免疫调节作用是由乳杆菌的代谢物介导的,例如短链脂肪酸,特别是丙酸盐、乙酸盐和丁酸盐。这些后生元与肠上皮细胞上的特定受体结合,以抑制嗜中性粒细胞和巨噬细胞的促炎活性和Treg抑制作用。
丁酸盐灌肠剂已被证明有效并成为转移性结肠炎的公认治疗方法,尽管这被认为是由于对平滑肌的松弛作用。
减少氧化应激作用
乳酸杆菌还能够产生抗氧化剂,如谷胱甘肽 (GSH),并能减少氧化应激。在结肠炎大鼠模型中,保加利亚乳杆菌的两个菌株已被证明可以减少脂质过氧化,增加抗氧化酶的测量值,并减少氧化应激。
在胃损伤小鼠模型中,发酵乳杆菌(L.fermentum Suo)显著降低了丙二醛(一种氧化损伤的量度)浓度和IL-6、IL-12、TNF-α 和IFN-γ的血清浓度。
在健康的人类受试者中,干酪乳杆菌与益生元菊粉一起服用,显著降低了丙二醛和谷胱甘肽二硫化物(另一种氧化测量)的浓度,并增加了抗氧化指标的浓度。
✦分泌蛋白化合物调节免疫
乳杆菌还可以通过分泌蛋白质化合物来调节免疫系统。从鼠李糖乳杆菌(L. rhamnosus GG ATCC 53103)释放的蛋白质p40和p75都激活了Akt信号通路,抑制了肿瘤坏死因子诱导的人和小鼠结肠上皮细胞和小鼠结肠外植体细胞凋亡。
减少炎症损伤
在诱导小鼠结肠炎之前用鼠李糖乳杆菌进行预处理可显著减少结肠炎症和损伤,抑制细胞因子诱导的细胞凋亡并减少过氧化氢诱导的紧密连接破坏。
在鼠李糖乳中发现的两种可溶性蛋白质p40和p75的消耗消除了这些抗炎作用。鼠李糖乳杆菌通过分泌可溶性肽增加小鼠结肠细胞中热休克蛋白HSP25和 HSP72 的产生,这些肽通过激活MAPK信号转导途径发挥作用。
03
乳杆菌与阴道健康
乳杆菌属不仅在人体肠道健康中起着重要作用,在女性阴道健康与相关疾病中的作用也不容忽视。
阴道微生物组在人类阴道健康方面起着重要作用。使用高通量宏基因组和16S rRNA测序,已在人类阴道中鉴定出超过250种细菌。
其中,乳杆菌是健康阴道中最常检测到的微生物,包括卷曲乳杆菌、惰性乳杆菌、詹氏乳杆菌和格氏乳杆菌。
几十年来,乳杆菌通过产生有机酸、细菌素和其他抗菌化合物来防止病原体入侵,被认为对阴道生态有益。
▼ 阴道微生物组成
健康阴道中主要乳杆菌的相对丰度决定了细菌群落群的类型,称为群落状态类型(CST)。群落状态类型分为CST I、II、III、IV、V五种。
每个群落均由卷曲乳杆菌(L. crispatus)、加氏乳杆菌(L. gasseri)、惰性乳杆菌(L. iners)、包括乳杆菌和细菌性阴道病相关细菌(BVAB)在内的多种微生物群落占主导地位。
✦阴道微生物群会随时间和外因变化
人类阴道微生物群组成在不同的生命阶段会发生变化,包括婴儿、青春期、怀孕和更年期。
荷尔蒙的变化、抗生素的不受控制的使用、月经和阴道冲洗是导致人类阴道微生物群暂时变化的常见因素。
阴道生态系统破坏的特征是乳杆菌种类的枯竭和非乳杆菌微生物的过度生长。通常,厌氧菌的过度生长会导致异常情况,例如细菌性阴道病以及妊娠相关并发症。
▼ 乳杆菌与阴道菌群失调
与肠道菌群相比,健康个体阴道微生物环境的一个典型特征是较低的细菌多样性。阴道生态失调的定义是细菌多样性高和厌氧菌混合,通常与多种妇科疾病有关。
惰性乳杆菌(L. iners)存在于健康女性的阴道中,或者存在于阴道生态失调的女性中,例如细菌性阴道病,甚至在接受抗菌治疗的女性中。
▷乳杆菌的丰度与阴道健康有关
许多研究报告说,卷曲乳杆菌(L. crispatus)在阴道中的存在与身体健康有关,而以惰性乳杆菌(L. iners)为主的群落无法提供足够的保护以防止阴道生态失调。
惰性乳杆菌与炎症反应有关
惰性乳杆菌的存在与较高水平的促炎因子有关,例如白细胞介素-1α、白细胞介素-18、巨噬细胞迁移抑制因子和肿瘤坏死因子,它们负责激活阴道中的炎症反应。
惰性乳杆菌甚至被认为在阴道生态失调中起作用,尽管惰性乳杆菌的确切作用仍有争议。然而,惰性乳杆菌的丰度似乎保持相对恒定,惰性乳杆菌不易被病原体或感染条件取代。
惰性乳杆菌在各种条件下的卓越生存能力表明该物种可能是宿主防御的重要成员,并且可能是一种持久的共生乳杆菌可以维持和恢复阴道微生物组的物种。
▼ 乳杆菌与细菌性阴道病
细菌性阴道病是育龄妇女最常见的阴道炎类型。它的特点是乳杆菌种类显著减少或消失,伴随着以厌氧和兼性厌氧细菌为主的更多样化的微生物群的出现,例如加德纳菌属、普雷沃氏菌属和阴道曲霉。
注:惰性乳杆菌通常是唯一可以在细菌性阴道病期间检测到的与细菌性阴道病相关细菌共存的阴道乳杆菌。由于其能够响应和调节其基因组功能,它可以在细菌性阴道病急剧变化的阴道环境下持续存在。
▷惰性乳杆菌作为微生物指标
由于惰性乳杆菌在细菌性阴道病中共存,惰性乳杆菌的流行可以作为预测细菌性阴道病发病或中期状态的微生物指标。
此外,惰性乳杆菌对甲硝唑具有抗性,即使在用甲硝唑处理后也是阴道中主要的乳杆菌属物种。惰性乳杆菌显示出更强的竞争优势并共存于被破坏的微生物组中。
因此,惰性乳杆菌的持久性可能会导致长期的阴道生态失调,尤其是在重复治疗周期后。需要进一步的研究来阐明该物种是否只是阴道微生物群转变的生物标志物或细菌性阴道病的促成因素。
尽管如此,最近的一项研究发现了一种名为副格氏乳杆菌(Lactobacillus paragasseri)的人类肠道菌株产生的三种细菌素活性肽。
这些细菌素对惰性乳杆菌具有很强的选择性抑制活性,而卷曲乳杆菌(L. crispatus)、加氏乳杆菌(L. gasseri)和詹氏乳杆菌(L. jensenii)仅受到轻微抑制,表明这些乳杆菌衍生的惰性乳杆菌有效抑制剂可以与甲硝唑联合使用,以改善目前的治疗
▷抗生素和乳杆菌组合可显著降低复发率
传统的治疗方法是使用甲硝唑等抗生素。事实上,口服甲硝唑治疗后的复发率非常高,全身使用抗生素有很大的副作用。在这种情况下,急需新的治疗策略。
益生菌的使用可以改善阴道菌群,增加有益菌,减少有害菌的数量,进一步维持阴道菌群环境的稳定。如今,越来越多的证据表明益生菌可有效治疗 细菌性阴道病。
在对30项研究的荟萃分析中,发现益生菌干预降低了复发率,提高了治愈率。
在另一项荟萃分析中,发现与单独使用抗生素相比,抗生素和益生菌的组合使用可显著降低细菌性阴道病的复发率。
乳杆菌在治疗细菌性阴道病的临床研究

Mei Z,et al.Front Cell Infect Microbiol.2022
▼ 乳杆菌与生物膜
生物膜是紧密附着在细菌表面的结构,已知它们比一般细胞对宿主免疫反应和抗生素治疗更具抵抗力。
▷生物膜与阴道感染相关
已经表明,阴道上皮细胞上的生物膜形成与阴道感染密切相关。有足够的证据表明细菌性阴道病与多种微生物生物膜的存在有关。
据推测,加德纳菌属(Gardnerella spp.)启动了生物膜的形成,这支持其他细菌性阴道病相关细菌(BVAB)附着在阴道上皮上,进一步增强了生物膜厚度。
此外,加德纳菌生物膜是抗生素的屏障,通过阻止抗生素的渗透来保护其他其他细菌性阴道病相关细菌。人们普遍认为,细菌性阴道病的高复发率是由于生物膜的形成,生物膜可以保护细菌免受抗生素治疗。
▷乳杆菌可以在一定程度上清除生物膜
先前的研究使用了乳杆菌,试图清除多微生物生物膜,并抑制人类阴道中的感染。
据报道,植物乳杆菌可显著降低HT-29细胞系中大肠杆菌、鼠伤寒沙门氏菌、金黄色葡萄球菌和铜绿假单胞菌的粘附,这使其成为治疗细菌性阴道病的潜在抗生物膜剂。
卷曲乳杆菌(L.crispatus)大大降低了来自健康女性和患有细菌性阴道病女性的阴道加特纳菌(G.vaginalis)对宫颈上皮细胞的粘附。
需要注意的是,惰性乳酸杆菌(L. iners)显著降低了健康女性阴道加特纳菌的粘附力,但增强了致病性阴道加特纳菌的粘附。表明惰性乳酸杆菌可以与细菌性阴道病相关的加特纳菌共存,并可能有助于阴道加特纳菌主导的生物膜形成。
进一步了解阴道共生乳杆菌与生物膜的结构和功能之间的相互作用,对于确定生物膜相关感染的新治疗方法至关重要。
▼ 乳杆菌与宫颈癌
宫颈癌是女性生殖道的恶性肿瘤,每年约有30万人死于宫颈癌。
▷感染人乳头瘤病毒后破坏阴道微生态
感染人乳头瘤病毒(HPV)后,可破坏阴道微生态平衡,使乳杆菌数量减少,增加异常菌群的粘附定植。这进一步导致人乳头瘤病毒蛋白表达上调,促进宫颈上皮内瘤变(CIN)的发展,甚至导致宫颈癌的发生。
研究发现HPV阳性女性的阴道细菌多样性更为复杂,阴道微生物群的组成也不同。持续的高危型HPV感染和宫颈微环境的改变加快了宫颈癌前病变的发生发展。
▷乳杆菌对抵抗宫颈癌具有抵抗作用
一项研究首次证明口服卷曲乳杆菌(Lactobacillus curlicus)可以改变阴道群落状态类型并增加HPV清除率。
乳杆菌作为一种阴道益生菌,不仅可以酸化阴道环境,稳定阴道菌群,增强阴道上皮细胞功能,还可以杀灭宫颈癌细胞。增加益生菌摄入量与减缓癌症进展之间存在重要联系。
乳酸菌激活免疫系统,通过分泌多种抗肿瘤代谢物,包括磷酸化多糖和细胞外多糖,抑制恶性肿瘤的增殖。
抑制癌细胞增殖
乳杆菌吸附并占据阴道上皮,防止引起恶性肿瘤的侵袭性病原菌的粘附。乳酸菌可以通过分泌肽聚糖和胞外多糖来抑制癌细胞增殖。
促进细胞因子产生
乳杆菌主要是增强机体的免疫过程,促进细胞因子的产生,抑制单核细胞的增殖。最近的研究表明,乳杆菌如干酪乳杆菌和鼠李糖乳杆菌通过激活自然杀伤细胞和树突状细胞的成熟发挥抗癌作用。
影响体液免疫和细胞免疫
乳杆菌还能影响细胞免疫和体液免疫,促进胸腺源性细胞的增殖和分化,进一步促进骨髓源性细胞的免疫识别和增殖。
对宫颈癌细胞具有细胞毒性
此外,乳杆菌代谢物对宫颈癌细胞也有细胞毒作用。乳酸杆菌的增加属与高危亚型HPV感染、宫颈上皮内瘤变和癌检出率下降有关。
微生物群在癌症的治疗中发挥着越来越重要的作用。乳酸菌作为一种很有前途的非化疗替代疗法,在恢复和维持正常阴道菌群和治疗宫颈癌方面引起了广泛关注。下面总结了一些乳杆菌对宫颈癌细胞的作用:
乳杆菌在宫颈癌中的作用研究

编辑
Mei Z,et al.Front Cell Infect Microbiol.2022
▼ 乳杆菌与月经周期
月经周期是扰乱阴道微生物组多样性的最重要因素之一。卷曲乳杆菌(L.crispatus)通常在育龄妇女的阴道中占据主导地位,而惰性乳杆菌(L.iners)在月经周期期间过度生长并取代卷曲乳杆菌。
▷月经期间阴道微生物变化显著
最近的一项研究报告说,惰性乳杆菌(L.iners)是卵泡期最常见的微生物;惰性乳杆菌和CST IV类型(微生物多样性)在排卵期占主导地位;在黄体期,最常见的类型也是CST IV。
事实上,惰性乳杆菌的丰度在月经期间显著增加,通常与阴道加特纳菌或阴道阿托波氏菌(Atopobium vaginae)的增加有关;然而,在没有干预的情况下,它们随后会在月经后减少。
▷感染人乳头瘤病毒后破坏阴道微生态
由于阴道微生物的动态变化,在同一个体月经周期的不同时间具有不同特征,因此月经周期的采样时刻对于阴道群落分析非常重要。
▼ 乳杆菌与早产
在怀孕期间保持阴道微生物群中乳杆菌的自然和健康平衡尤为重要。早期的研究证实,怀孕期间阴道中的高雌二醇水平和随之而来的高糖原水平会导致阴道酸化更强,从而随着妊娠的进展促进乳杆菌属的流行。
▷怀孕期间阴道微生物可能存在失调
许多研究表明,以惰性乳杆菌(L.iners)为主的阴道微生物组在怀孕期间更有可能转向生态失调。研究发现,在健康孕妇的孕中期和孕晚期,惰性乳杆菌的丰度显著下降,而卷曲乳杆菌(L.crispatus)的丰度在孕中期与孕早期相比有所增加。
▷乳杆菌丰度与早产直接存在关联
越来越多的证据表明细菌性阴道病是导致不良妊娠结局的主要原因之一,尤其是早产。惰性乳杆菌占主导地位的阴道微生物组,被推测是早产的危险因素。
怀孕早期健康女性的阴道涂片中检测到的惰性乳杆菌可能与早产有关。一项研究报告称,在妊娠16周时,由惰性乳杆菌主导的阴道微生物组是短宫颈和早产(<34周)的一个风险因素。
在更具种族多样性的队列中,卷曲乳杆菌的主导地位对早产具有保护作用。来自不同国家的最新研究也表明,乳杆菌与早产发病率增加之间存在显著关联。

▼ 乳杆菌与不孕症
先前的研究报告称,在体外受精辅助生殖失败的患者中,高达40%的患者有异常的生殖道微生物组。
阴道生态失调,包括pH值升高、菌群多样性增加、细菌性阴道病、外阴阴道念珠菌病和滴虫性阴道炎,被认为是不孕的危险因素。
▷惰性乳杆菌丰度与不孕相关
一项研究报告称,惰性乳杆菌的丰度与不孕率的增加有关。最近还报道了以惰性乳杆菌为主的阴道微生物组与输卵管性不孕症和沙眼衣原体感染有关。人们认为,以惰性乳杆菌(L. iners)为主的阴道微生物组是怀孕的不利因素。
04
乳杆菌与其他疾病
乳杆菌属作为人体数量最多的细菌之一,不仅仅只是影响了肠道和阴道健康,在全身其他疾病中也有一定作用。
▼ 乳杆菌与特应性皮炎
特应性皮炎(AD)是一种慢性炎症性皮肤病,患者经常会因并发过敏性疾病而出现并发症。
尽管特应性皮炎的发病机制尚不清楚,但数十年的研究表明,特应性皮炎的发病机制可能与遗传因素、环境暴露、皮肤屏障受损、免疫功能异常和微生物失衡有关。
•乳杆菌在预防和治疗特应性皮炎中发挥作用
肠道在免疫反应中起着重要作用。乳杆菌是应用最广泛的益生菌。已经研究了几种乳杆菌用特应性皮炎预防和治疗。
乳杆菌通过对致病菌的竞争性排斥和抗菌活性,刺激先天免疫,促进微生物群落平衡。
据报道,这些乳杆菌可以产生多种物质,如有机酸、过氧化氢、低分子量抗菌剂、细菌素和粘附抑制剂。
乳杆菌的给药降低了免疫球蛋白E(IgE)的血清水平,并实现了Th1/Th2的平衡。乳杆菌加速免疫系统的成熟,维持肠道稳态,改善肠道微生物群,最终改善特应性皮炎症状。
用于治疗和预防特应性皮炎的乳杆菌

Xie A,et al.Front Cell Infect Microbiol.2023
肠道屏障、免疫功能和皮肤屏障在给予乳杆菌后得到了改善。下面列出了一些乳杆菌的作用机制。乳杆菌对患有特应性皮炎的动物和人类都显示出一定的作用。
乳杆菌治疗特应性皮炎的作用



编辑
Xie A,et al.Front Cell Infect Microbiol.2023
▼ 乳杆菌与牙周疾病
肠道微生物群在调节影响全身健康的宿主代谢中起着关键作用。迄今为止,多项研究证实了微生物群与宿主相互作用、调节免疫、控制稳态环境和维持全身状况。
据报道,植物乳杆菌(L. plantarum)具有将亚油酸转化为共轭亚油酸的潜力。根据分子和化学结构,乳杆菌通过多不饱和脂肪酸过程产生的代谢物为10-羟基-顺式-12-十八烯酸(HYA)、10-羟基-十八烯酸(HYB)、10-羟基-反式-11-十八烯酸 (HYC)、10-氧代-顺式-12-十八碳烯酸(KetoA)、10-氧代-十八烷酸(KetoB)和10-氧代-反式 -11-十八碳烯酸 KetoC )。
•乳杆菌代谢物有益于牙周稳态
乳杆菌衍生的生物活性代谢物能带来牙周稳态。HYA和KetoC具有抗氧化、抗炎、抗菌和上皮屏障连接改善剂的作用。
乳杆菌的生物活性代谢物有助于牙周稳态

Sulijaya B,et al.Molecules.2020
• 乳杆菌也可能引起龋齿
虽然链球菌家族细菌(例如变形链球菌)是蛀牙的最常见原因,其他种类的微生物也会引起龋齿。例如,一些乳杆菌属物种与龋齿病例有关。乳酸具有腐蚀牙齿的能力,唾液中的乳杆菌数多年来一直被用作“龋齿测试”。
这是支持在牙膏中使用氟化物的论据之一。乳杆菌的特征是导致现有的龋齿病变进展,尤其是那些在冠状龋齿中的病变。
然而,这个问题很复杂,因为最近的研究表明益生菌可以让有益的乳酸杆菌在牙齿上生长,防止链球菌病原体占据并导致蛀牙。
乳酸菌与口腔健康相关的科学研究是一个新领域,目前发表的研究和结果还很少,需要更多研究。
▼ 乳酸菌与呼吸系统疾病
呼吸道感染是世界上发病率和死亡率最高的疾病之一。尽管许多呼吸道感染具有轻微和自限性,但它们每年在全世界造成400万人死亡。
最近几年严重急性呼吸系统综合症冠状病毒2(也称新型冠状病毒) 在全球肆虐。许多呼吸道病原体没有有效的疫苗,耐药微生物的增加使得呼吸道感染的有效治疗极具挑战性。因此,找到一种安全有效的方法来降低呼吸道感染的风险是很重要的。
•乳杆菌通过肠肺轴影响呼吸系统健康
近年来,许多研究报道肠和肺之间存在串扰,这种被描述为肠-肺轴的联系似乎是双向的 。口服一些益生菌,尤其是乳杆菌,可以通过肠肺轴促进呼吸系统健康。
乳酸杆菌通过肠肺轴调节呼吸免疫的潜在机制

Du T,et al.Front Immunol.2022
最近,乳杆菌已被用于对抗各种呼吸道感染,包括病毒和细菌感染。许多乳杆菌显示可以预防流感病毒感染,包括以下菌株:
L. rhamnosus GG、
L.casei Shirota、
L. plantarum DK119、
L. paracasei MCC1849、
L. gasseri SBT2055、
L. fermentum CJl-112、
L. kunkeei YB38。
此外,乳酸菌由于其安全性和生物技术优势,作为疫苗或佐剂在预防流感病毒感染方面也具有出色的作用。
值得注意的是,补充相同乳杆菌菌株(如鼠李糖乳杆菌CRL1505)的活菌和灭活菌通常具有相似的效果, 表明活力对于乳酸菌达到保护性免疫调节作用不是必需的。
下面是一些通过施用乳杆菌来预防细菌或病毒性呼吸道感染的研究:
乳杆菌预防细菌和病毒性呼吸道感染的研究



Du T,et al.Front Immunol.2022
▼ 乳杆菌与系统性红斑狼疮
系统性红斑狼疮是一种慢性自身免疫性疾病,影响大约一半患者的肾脏。狼疮性肾炎(LN)是系统性红斑狼疮发病和死亡的重要危险因素。
狼疮性肾炎与肠壁充血、代谢性酸中毒、频繁使用抗生素有关,所有这些都会对肠道紧密连接产生影响,并导致穿过肠道屏障的细菌代谢产物增加。此外,胃肠道尿素输出增加导致肠道微生物失调。
•乳杆菌混合物有助于恢复黏膜屏障减少肾脏病变
研究发现,5种乳杆菌的混合物(Lactobacillus oris、Lactobacillus rhamnosus、Lactobacillus reuteri、Lactobacillus johnsonii和Lactobacillus gasseri) 通过增加调节性T细胞和抑制致病性Th17细胞来恢复粘膜屏障功能并减少肾脏病变。
表明乳杆菌和乳杆菌衍生的生物活性代谢物在治疗系统性红斑狼疮中具有潜在有益功能。
乳杆菌及其代谢物在系统性红斑狼疮中的有益作用

Wang W,et al.Front Immunol.2022
05
如何调节乳杆菌

doi.org/10.1016/j.foodres.2022.111809
▼ 补充乳杆菌
乳杆菌在人体健康以及一些疾病中起着重要的作用,作为人体不可缺少的一种细菌,我们应该如何补充呢?以下是一些补充乳杆菌的方法:
常见水果
水果中的生物活性物质,包括如胡萝卜素、多酚化合物、维生素和纤维素等,富含这些生物活性物质的水果如香蕉、木莓(树莓)、苹果、芒果、柠檬、石榴、木瓜、猕猴桃等,可以促进乳杆菌属的生长。

食用发酵食品
酸奶、奶酪、酸菜、泡菜、开菲尔、味噌、豆豉等发酵食品中含有丰富的乳杆菌,可以通过食用这些食品来补充乳杆菌。
益生菌
市面上有很多乳杆菌制剂,如乳杆菌素、乳酸菌片等,可以通过口服来补充乳杆菌。
由于补充剂含有不同数量的细菌,因此请阅读包装上的说明。根据补充剂中微生物的数量适量补充。
如果正在服用抗生素,请在抗生素服用2小时之前或者2小时之后服用乳杆菌制剂。
益生元
益生元是一种可以促进肠道内有益菌生长的物质,可以通过食用含有益生元的食品来促进乳杆菌的生长。例如低聚半乳糖(GOS)、低聚果糖(FOS)和母乳低聚糖(HMO)等。
从牛蒡中提取的菊粉促进了有益细菌的生长。菊粉显着增加了小鼠中的乳酸杆菌和双歧杆菌。
将龙舌兰中菊粉等果聚糖添加到正常小鼠饮食中,发现小鼠体内乳酸菌、双歧杆菌数量增加。
全麦谷物可以增加双歧杆菌和乳酸杆菌的相对数量。
一项临床试验(NCT02227602),10名参与者连续8周每天服用200-400克芒果果肉,显著增加乳杆菌、植物乳杆菌、罗伊氏乳杆菌和乳酸乳杆菌的丰度。
还包括其他一些常见食物,例如大蒜、洋葱、韭菜、芦笋、全谷物等,都有助于促进肠道中乳杆菌的生长。

合生元
一项临床试验(NCT 编号:03123510),20 名受试者在接受合生元3个月后,乳杆菌和双歧杆菌显著增加。
注:该研究中的合生元:益生菌成分含有嗜酸乳杆菌DDS-1、乳酸双歧杆菌UABla-12、长双歧杆菌UABl-14和两歧双歧杆菌UABb-10的专利菌株的混合物,益生元成分是一种反式低聚半乳糖混合物。
其他补充剂
乳清和豌豆蛋白的摄入可以增加双歧杆菌和乳酸杆菌的丰度。
灵芝孢子油具有很强的免疫增强活性,有助于肠乳杆菌丰度升高。
绿茶与异麦芽低聚糖联合使用,通过预防小鼠肠道生态失调来对抗高脂肪饮食诱导的代谢改变,双歧杆菌、乳杆菌、罗氏菌属丰度升高。
补充维生素A、维生素C都可以使乳酸杆菌增加。
姜黄素、白藜芦醇、杏仁/杏仁皮可以增加乳酸杆菌。
膳食褐藻糖胶可以增加乳酸杆菌和瘤胃球菌科的丰度。
补充2周葡萄多酚显著提高了断奶后小鼠的乳酸杆菌和Akkermansia的丰度。

中医
对溃疡性结肠炎的患者应用益阳愈溃汤结合针刺治疗,对照组仅给予益阳愈溃汤,治疗后实验组双歧杆菌、乳酸杆菌等均高于对照组。
在连续给药3周后,黄芩促进大鼠结肠的乳酸菌的生长。栀子对乳酸菌双向调节。
黄柏对大鼠肠道乳酸菌的影响:整体表现为促进。
黄连提取物显著促进乳酸菌、双歧杆菌的生长。
吴茱萸碱(EVO)是从吴茱萸中分离出的喹诺酮类生物碱,通过增加嗜酸乳杆菌水平和乙酸盐产生对溃疡性结肠炎具有治疗效果。
山药多糖灌胃健康小鼠一段时间后,发现小鼠盲结肠内的双歧杆菌、乳酸菌均增殖。
马齿苋多糖可使衰老小鼠肠道双歧杆菌及乳酸杆菌数量增加。
蒲公英多糖、黄芪多糖能改善小鼠菌群失调,显著增加双歧杆菌和乳酸杆菌数量。
麦冬多糖 MDG-1 对膳食诱导型肥胖小鼠肠道益生菌群有增殖作用,尤其是一些鼠乳杆菌和台湾乳杆菌。
魔芋低聚糖对三硝基苯磺酸 (TNBS) 诱导溃疡性结肠炎大鼠有保护机制,结肠内乳酸杆菌和双歧杆菌数量增多。
泰山蛹虫草多糖对环磷酰胺 (CY) 免疫抑制小鼠的作用,发现多糖组双歧杆菌、乳酸菌数量均较 CY 模型组增加。
七味白术散能促进小鼠肠道乳酸菌和双歧杆菌的增殖(P<0.05),恢复肠道菌群平衡。
肺癌患者放射治疗后服用养阴清肺汤,治疗12周后,乳酸菌和双歧杆菌含量较对照组均上升(P<0.05)。

▼ 与乳杆菌降低相关
辣椒素可降低2型糖尿病小鼠体内乳酸杆菌的丰度。
高盐饮食会使乳酸杆菌的丰度降低。
一些疾病的存在可能与乳杆菌降低相关:
包括阿尔茨海默症、自闭症、炎症性肠病、慢性肝病、过敏疾病、肿瘤、肥胖、牙周病、免疫缺陷病、干燥综合征、系统性红斑狼疮、类风湿关节炎、肾脏疾病等。
注意
虽然乳杆菌在大部分情况下对人体都是有益的,但是过量补充也是不可取的。那么我们如何知道自己体内的乳杆菌含量以及补充是否足够呢?
✔肠道菌群检测可以直观地反映体内乳杆菌丰度
肠道菌群检测是目前较为直观地反映补充剂和食物对肠道乳杆菌影响的方法,通过使用高通量测序技术评估肠道中乳杆菌的菌群丰度。
如果通过检测发现乳杆菌处于正常水平,则不需要额外补充,过高的乳杆菌水平并不一定代表更健康;如果发现乳杆菌缺乏,那么可以通过前文所讲的方法进行补充,有助于营造更健康的身体。
补充乳杆菌并不是一劳永逸的事情,需要长期坚持。同时,对于某些人群,如免疫力低下、肠道疾病患者等,应在医生的指导下进行补充。
06
结语
总之,乳杆菌是一类非常重要的益生菌,它们能够帮助我们维护肠道和阴道的健康、提高免疫力、改善消化功能,并且可有效治疗各种疾病,包括细菌性阴道病、特应性皮炎和呼吸道感染,对人体健康有着重要的作用。
我们可以通过食用富含乳杆菌的食物或者补充乳杆菌制剂来增加体内乳杆菌的数量,从而更好地保护我们的健康。
此外,乳杆菌对于食品、化工业、保健品和医药行业也都具有重要价值。有必要进一步研究乳杆菌,在未来发掘它更深层的价值。
附录一:乳杆菌种类
· Lactobacillus acetotolerans
· Lactobacillus acidifarinae
· Lactobacillus acidipiscis
· Lactobacillus acidophilus
· Lactobacillus agilis
· Lactobacillus algidus
· Lactobacillus alimentarius
· Lactobacillus alvei
· Lactobacillus alvi
· Lactobacillus amylolyticus
· Lactobacillus amylophilus
· Lactobacillus amylotrophicus
· Lactobacillus amylovorus
· Lactobacillus animalis
· Lactobacillus animata
· Lactobacillus antri
· Lactobacillus apinorum
· Lactobacillus apis
· Lactobacillus apodemi
· Lactobacillus aquaticus
· Lactobacillus aviarius
· Lactobacillus backii
· Lactobacillus bifermentans
· Lactobacillus bombi
· Lactobacillus bombicola
· Lactobacillus brantae
· Lactobacillus brevis
· Lactobacillus brevisimilis
· Lactobacillus buchneri
· Lactobacillus cacaonum
· Lactobacillus camelliae
· Lactobacillus capillatus
· Lactobacillus casei group
· Lactobacillus catenefornis
· Lactobacillus ceti
· Lactobacillus coleohominis
· Lactobacillus collinoides
· Lactobacillus composti
· Lactobacillus concavus
· Lactobacillus coryniformis
· Lactobacillus crispatus
· Lactobacillus crustorum
· Lactobacillus curieae
· Lactobacillus curvatus
· Lactobacillus delbrueckii
· Lactobacillus dextrinicus
· Lactobacillus diolivorans
· Lactobacillus equi
· Lactobacillus equicursoris
· Lactobacillus equigenerosi
· Lactobacillus fabifermentans
· Lactobacillus faecis
· Lactobacillus faeni
· Lactobacillus farciminis
· Lactobacillus farraginis
· Lactobacillus fermentum
· Lactobacillus floricola
· Lactobacillus florum
· Lactobacillus formosensis
· Lactobacillus fornicalis
· Lactobacillus fructivorans
· Lactobacillus frumenti
· Lactobacillus fuchuensis
· Lactobacillus furfuricola
· Lactobacillus futsaii
· Lactobacillus gallinarum
· Lactobacillus gasseri
· Lactobacillus gastricus
· Lactobacillus ghanensis
· Lactobacillus gigeriorum
· Lactobacillus ginsenosidimutans
· Lactobacillus gorillae
· Lactobacillus graminis
· Lactobacillus guizhouensis
· Lactobacillus halophilus
· Lactobacillus hammesii
· Lactobacillus hamsteri
· Lactobacillus harbinensis
· Lactobacillus hayakitensis
· Lactobacillus heilongjiangensis
· Lactobacillus helsingborgensis
· Lactobacillus helveticus
· Lactobacillus herbarum
· Lactobacillus heterohiochii
· Lactobacillus hilgardii
· Lactobacillus hokkaidonensis
· Lactobacillus hominis
· Lactobacillus homohiochii
· Lactobacillus hordei
· Lactobacillus iatae
· Lactobacillus iners
· Lactobacillus ingluviei
· Lactobacillus insectis
· Lactobacillus insicii
· Lactobacillus intermedius
· Lactobacillus intestinalis
· Lactobacillus iwatensis
· Lactobacillus japonicus
· Lactobacillus jensenii
· Lactobacillus johnsonii
· Lactobacillus kalixensis
· Lactobacillus kefiranofaciens
· Lactobacillus kefiri
· Lactobacillus kimbladii
· Lactobacillus kimchicus
· Lactobacillus kimchiensis
· Lactobacillus kisonensis
· Lactobacillus kitasatonis
· Lactobacillus koreensis
· Lactobacillus kullabergensis
· Lactobacillus kunkeei
· Lactobacillus larvae
· Lactobacillus leichmannii
· Lactobacillus letivazi
· Lactobacillus lindneri
· Lactobacillus malefermentans
· Lactobacillus mali
· Lactobacillus manihotivorans
· Lactobacillus mellifer
· Lactobacillus mellis
· Lactobacillus melliventris
· Lactobacillus mindensis
· Lactobacillus mixtipabuli
· Lactobacillus mobilis
· Lactobacillus mucosae
· Lactobacillus mudanjiangensis
· Lactobacillus murinus
· Lactobacillus nagelii
· Lactobacillus namurensis
· Lactobacillus nantensis
· Lactobacillus nasuensis
· Lactobacillus nenjiangensis
· Lactobacillus nodensis
· Lactobacillus odoratitofui
· Lactobacillus oeni
· Lactobacillus oligofermentans
· Lactobacillus oris
· Lactobacillus oryzae
· Lactobacillus otakiensis
· Lactobacillus ozensis
· Lactobacillus panis
· Lactobacillus pantheris
· Lactobacillus parabrevis
· Lactobacillus parabuchneri
· Lactobacillus paracasei
· Lactobacillus paracollinoides
· Lactobacillus parafarraginis
· Lactobacillus parakefiri
· Lactobacillus paralimentarius
· Lactobacillus paraplantarum
· Lactobacillus pasteurii
· Lactobacillus paucivorans
· Lactobacillus pentosus
· Lactobacillus perolens
· Lactobacillus plantarum
· Lactobacillus pobuzihii
· Lactobacillus pontis
· Lactobacillus porcinae
· Lactobacillus psittaci
· Lactobacillus rapi
· Lactobacillus rennanquilfy
· Lactobacillus rennini
· Lactobacillus reuteri
· Lactobacillus reuterii
· Lactobacillus rhamnosus
· Lactobacillus rodentium
· Lactobacillus rogosae
· Lactobacillus rossiae
· Lactobacillus ruminis
· Lactobacillus saerimneri
· Lactobacillus sakei
· Lactobacillus salivarius
· Lactobacillus sanfranciscensis
· Lactobacillus saniviri
· Lactobacillus satsumensis
· Lactobacillus secaliphilus
· Lactobacillus selangorensis
· Lactobacillus senioris
· Lactobacillus senmaizukei
· Lactobacillus sharpeae
· Lactobacillus shenzhenensis
· Lactobacillus sicerae
· Lactobacillus silagei
· Lactobacillus siliginis
· Lactobacillus similis
· Lactobacillus songhuajiangensis
· Lactobacillus sp.
· Lactobacillus sp. 66c
· Lactobacillus sp. 7_1_47FAA
· Lactobacillus sp. Akhmro1
· Lactobacillus sp. BL302
· Lactobacillus sp. C30An8
· Lactobacillus sp. C4I18
· Lactobacillus sp. C4I5
· Lactobacillus sp. CR-609S
· Lactobacillus sp. NRCT-KU 1
· Lactobacillus sp. S16
· Lactobacillus sp. TAB-22
· Lactobacillus sp. TAB-26
· Lactobacillus sp. TAB-30
· Lactobacillus sp. Thmro2
· Lactobacillus sp. oral taxon 052
· Lactobacillus sp. oral taxon 461
· Lactobacillus sp.A A18
· Lactobacillus sp.A A21
· Lactobacillus sp.A A25
· Lactobacillus sp.A A29
· Lactobacillus sp.A A35
· Lactobacillus sp.A A44
· Lactobacillus sp.A A45
· Lactobacillus sp.A A48
· Lactobacillus sp.A A49
· Lactobacillus sp.A A85
· Lactobacillus sp.A A96
· Lactobacillus sp.B A100
· Lactobacillus sp.B A101
· Lactobacillus sp.B A102
· Lactobacillus sp.B A103
· Lactobacillus sp.B A12
· Lactobacillus sp.B A13
· Lactobacillus sp.B A14
· Lactobacillus sp.B A16
· Lactobacillus sp.B A19
· Lactobacillus sp.B A20
· Lactobacillus sp.B A23
· Lactobacillus sp.B A31
· Lactobacillus sp.B A33
· Lactobacillus sp.B A34
· Lactobacillus sp.B A36
· Lactobacillus sp.B A37
· Lactobacillus sp.B A41
· Lactobacillus sp.B A42
· Lactobacillus sp.B A52
· Lactobacillus sp.B A53
· Lactobacillus sp.B A64
· Lactobacillus sp.B A65
· Lactobacillus sp.B A76
· Lactobacillus sp.B A78
· Lactobacillus sp.B A81
· Lactobacillus sp.B A86
· Lactobacillus sp.B A87
· Lactobacillus sp.B A89
· Lactobacillus sp.B A90
· Lactobacillus sp.B A91
· Lactobacillus sp.B A95
· Lactobacillus sp.B A97
· Lactobacillus sp.B A98
· Lactobacillus sp.B AB1
· Lactobacillus sp.B CG1
· Lactobacillus sp.B CG3
· Lactobacillus sp.B CG53
· Lactobacillus sp.B CG63
· Lactobacillus sp.B CG71
· Lactobacillus sp.B CG76
· Lactobacillus spicheri
· Lactobacillus sucicola
· Lactobacillus suebicus
· Lactobacillus sunkii
· Lactobacillus taiwanensis
· Lactobacillus thailandensis
· Lactobacillus tucceti
· Lactobacillus ultunensis
· Lactobacillus uvarum
· Lactobacillus vaccinostercus
· Lactobacillus vaginalis
· Lactobacillus vermiforme
· Lactobacillus versmoldensis
· Lactobacillus vini
· Lactobacillus wasatchensis
· Lactobacillus xiangfangensis
· Lactobacillus yonginensis
· Lactobacillus zymae
附录二:参与的KEGG途径
- 2-氧代羧酸代谢
- ABC转运体
- 丙氨酸、天冬氨酸和谷氨酸代谢
- 氨基糖和核苷酸糖代谢
- 氨酰-tRNA生物合成
- 氨基苯甲酸酯降解
- 精氨酸和脯氨酸代谢
- 精氨酸生物合成
- 细菌分泌系统
- 碱基切除修复
- 苯甲酸盐降解
- 氨基酸的生物合成
- 抗生素的生物合成
- 次级代谢物的生物合成
- 不饱和脂肪酸的生物合成
- 生物素代谢
- 丁酸代谢
- 碳代谢
- 阳离子抗菌肽 (CAMP) 耐药性
- 氯代烷烃和氯代烯烃降解
- 柠檬酸循环(TCA循环)
- 氰基氨基酸代谢
- 半胱氨酸和甲硫氨酸代谢
- D-丙氨酸代谢
- D-谷氨酰胺和D-谷氨酸代谢
- DNA复制
- 芳香族化合物的降解
- 脂肪酸生物合成
- 脂肪酸降解
- 脂肪酸代谢
- 叶酸生物合成
- 果糖和甘露糖代谢
- 半乳糖代谢
- 谷胱甘肽代谢
- 甘油脂代谢
- 甘油磷脂代谢
- 甘氨酸、丝氨酸和苏氨酸代谢
- 糖酵解/糖异生
- 乙醛酸和二羧酸代谢
- 同源重组
- 胰岛素抵抗
- 赖氨酸生物合成
- 赖氨酸降解
- 甲烷代谢
- 内酰胺生物合成
- 萘降解
- 烟酸盐和烟酰胺代谢
- 非核糖体肽结构
- 核苷酸切除修复
- 其他聚糖降解
- 氧化磷酸化
- 泛酸和 CoA 生物合成
- 戊糖和葡萄糖醛酸相互转化
- 戊糖磷酸途径
- 肽聚糖生物合成
- 磷酸转移酶系统 (PTS)
- 丙酸代谢
- 蛋白质输出
- 嘌呤代谢
- 嘧啶代谢
- 丙酮酸代谢
- RNA降解
- RNA聚合酶
- 核黄素代谢
- 核糖体
- 次级胆汁酸生物合成
- 硒化合物代谢
- 鞘脂代谢
- 淀粉和蔗糖代谢
- 链霉素生物合成
- 硫代谢
- 酮体的合成与降解
- 牛磺酸和亚牛磺酸代谢
- 萜类骨架生物合成
- 硫胺素代谢
- 酪氨酸代谢
- 缬氨酸、亮氨酸和异亮氨酸的生物合成
- 缬氨酸、亮氨酸和异亮氨酸降解
- 万古霉素耐药
- 维生素B6代谢
- β-内酰胺抗性
主要参考文献
Chee WJY, Chew SY, Than LTL. Vaginal microbiota and the potential of Lactobacillus derivatives in maintaining vaginal health. Microb Cell Fact. 2020 Nov 7;19(1):203. doi: 10.1186/s12934-020-01464-4. PMID: 33160356; PMCID: PMC7648308.
Zheng N, Guo R, Wang J, Zhou W, Ling Z. Contribution of Lactobacillus iners to Vaginal Health and Diseases: A Systematic Review. Front Cell Infect Microbiol. 2021 Nov 22;11:792787. doi: 10.3389/fcimb.2021.792787. PMID: 34881196; PMCID: PMC8645935.
Dempsey E, Corr SC. Lactobacillus spp. for Gastrointestinal Health: Current and Future Perspectives. Front Immunol. 2022 Apr 6;13:840245. doi: 10.3389/fimmu.2022.840245. PMID: 35464397; PMCID: PMC9019120.
Mei Z, Li D. The role of probiotics in vaginal health. Front Cell Infect Microbiol. 2022 Jul 28;12:963868. doi: 10.3389/fcimb.2022.963868. PMID: 35967876; PMCID: PMC9366906.
Chen CM, Wu CC, Huang CL, Chang MY, Cheng SH, Lin CT, Tsai YC. Lactobacillus plantarum PS128 Promotes Intestinal Motility, Mucin Production, and Serotonin Signaling in Mice. Probiotics Antimicrob Proteins. 2022 Jun;14(3):535-545. doi: 10.1007/s12602-021-09814-3. Epub 2021 Jul 29. PMID: 34327633; PMCID: PMC9076750.
Sulijaya B, Takahashi N, Yamazaki K. Lactobacillus-Derived Bioactive Metabolites for the Regulation of Periodontal Health: Evidences to Clinical Setting. Molecules. 2020 Apr 29;25(9):2088. doi: 10.3390/molecules25092088. PMID: 32365716; PMCID: PMC7248875.
Xie A, Chen A, Chen Y, Luo Z, Jiang S, Chen D, Yu R. Lactobacillus for the treatment and prevention of atopic dermatitis: Clinical and experimental evidence. Front Cell Infect Microbiol. 2023 Feb 16;13:1137275. doi: 10.3389/fcimb.2023.1137275. PMID: 36875529; PMCID: PMC9978199.
Wang W, Fan Y, Wang X. Lactobacillus: Friend or Foe for Systemic Lupus Erythematosus? Front Immunol. 2022 May 23;13:883747. doi: 10.3389/fimmu.2022.883747. PMID: 35677055; PMCID: PMC9168270.
Du T, Lei A, Zhang N, Zhu C. The Beneficial Role of Probiotic Lactobacillus in Respiratory Diseases. Front Immunol. 2022 May 31;13:908010. doi: 10.3389/fimmu.2022.908010. PMID: 35711436; PMCID: PMC9194447.
Sergeev IN, Aljutaily T, Walton G, Huarte E. Effects of Synbiotic Supplement on Human Gut Microbiota, Body Composition and Weight Loss in Obesity. Nutrients. 2020 Jan 15;12(1):222. doi: 10.3390/nu12010222. PMID: 31952249; PMCID: PMC7019807.
Kim H, Venancio VP, Fang C, Dupont AW, Talcott ST, Mertens-Talcott SU. Mango (Mangifera indica L.) polyphenols reduce IL-8, GRO, and GM-SCF plasma levels and increase Lactobacillus species in a pilot study in patients with inflammatory bowel disease. Nutr Res. 2020 Mar;75:85-94. doi: 10.1016/j.nutres.2020.01.002. Epub 2020 Jan 10. PMID: 32109839.
Wang MX, Lin L, Chen YD, Zhong YP, Lin YX, Li P, Tian X, Han B, Xie ZY, Liao QF. Evodiamine has therapeutic efficacy in ulcerative colitis by increasing Lactobacillus acidophilus levels and acetate production. Pharmacol Res. 2020 Sep;159:104978. doi: 10.1016/j.phrs.2020.104978. Epub 2020 May 30. PMID: 32485282.
Lu F, Li Y, Wang X, Hu X, Liao X, Zhang Y. Early-life polyphenol intake promotes Akkermansia growth and increase of host goblet cells in association with the potential synergistic effect of Lactobacillus. Food Res Int. 2021 Nov;149:110648. doi: 10.1016/j.foodres.2021.110648. Epub 2021 Aug 20. PMID: 34600650.
Borgonovi TF, Virgolin LB, Janzantti NS, Casarotti SN, Penna ALB. Fruit bioactive compounds: Effect on lactic acid bacteria and on intestinal microbiota. Food Res Int. 2022 Nov;161:111809. doi: 10.1016/j.foodres.2022.111809. Epub 2022 Aug 27. PMID: 36192952.
朱晨,段学清,段智璇,谢鑫,张其,田维毅.清热解毒中药黄芩和栀子对大鼠不同肠段菌群的影响[J].中华中医药学刊,2023,42(03):52-57.DOI:10.13193/j.issn.1673-7717.2023.03.012.
朱晨,陈瑞,谢鑫,张其,瞿慧琴,段学清,田维毅.黄柏对大鼠不同肠段主要菌群的影响[J].时珍国医国药,2021,32(12):2851-2855.
崔祥,陶金华,江曙,魏晓燕,徐君,钱大玮,段金廒.黄连提取物与肠道菌群的相互作用研究[J].中草药,2018,49(09):2103-2107.
周欣,付志飞,谢燕,王晓明,李楠,张鹏.中药多糖对肠道菌群作用的研究进展[J].中成药,2019,41(03):623-627.
谭周进,吴海,刘富林,蔡莹,蔡光先,张华玲,曾奥.超微七味白术散对肠道微生物及酶活性的影响[J].生态学报,2012,32(21):6856-6863.
潘婷婷,张爱琴.养阴清肺汤对肺癌患者放疗后皮肤损伤和肠道菌群的影响[J].辽宁中医杂志,2023,50(01):97-100.DOI:10.13192/j.issn.1000-1719.2023.01.028.
























 1438
1438

 被折叠的 条评论
为什么被折叠?
被折叠的 条评论
为什么被折叠?










